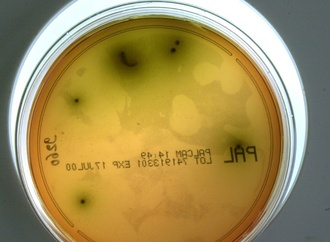
Rückruf von Lebensmitteln: Listerien sind häufigste Ursache

Das französische Luxus-Unternehmen Hermès war nach eigenen Angaben Ziel ungewöhnlicher Kontaktaufnahmen durch den US-Sexualstraftäter Jeffrey Epstein.
Das französische Luxus-Unternehmen Hermès war nach eigenen Angaben Ziel ungewöhnlicher Kontaktaufnahmen durch den US-Sexualstraftäter Jeffrey Epstein. Epstein habe sich 2013 einer Gruppe um den US-Filmemacher Woody Allen angeschlossen, obwohl er "nicht eingeladen" gewesen sei, sagte Hermès-Chef Axel Dumas am Donnerstag in Paris. Allen sei eingeladen gewesen, eine Werkstatt des Luxus-Unternehmens im Pariser Vorort Pantin zu besuchen. Dass er in Begleitung von Epstein komme, sei nicht angekündigt gewesen, sagte Dumas.
Diese Episode erkläre die Existenz eines Fotos, das ihn selbst neben Allen und Epstein zeigt und sich in den veröffentlichten Epstein-Akten fand. "Er hatte einen schlechten Ruf", sagte Dumas am Rande der Vorstellung der Unternehmenszahlen. Anschließend habe Epstein mehrfach um Treffen mit dem Hermès-Chef gebeten, was dieser abgelehnt habe. Dies ist durch Dokumente in den Epstein-Akten belegt.
Bereits 2012 habe Epstein Hermès gebeten, die Innenausstattung seines Privatjets zu übernehmen. Dies habe das Unternehmen ebenfalls abgelehnt. "Ich erinnere mich nicht mehr, was man über ihn damals wusste, aber er hatte schon damals einen schlimmen Ruf", sagte Dumas.
Einige Jahre später bot Epstein bei einer Versteigerung für einen guten Zweck mit und ersteigerte einen Kurs in einer Hermès-Werkstatt. "Als wir erfahren haben, wer der erfolgreiche Bieter war, haben wir dies storniert und die karitative Organisation entschädigt", sagte Dumas.
Seit der Veröffentlichung von drei Millionen Dokumenten aus den Epstein-Akten Ende Januar geraten immer mehr Politiker und Prominente unter Druck, die in den Dokumenten auftauchen. Eine Erwähnung in den Akten bedeutet jedoch noch keine Verwicklung in Epsteins Affären.
In Frankreich war zuletzt der ehemalige Kulturminister Jack Lang von der Leitung des Kukturinstituts Institut du Monde Arabe zurückgetreten. In den Epstein-Dokumenten fanden sich Hinweise auf ein Offshore-Unternehmen, die französische Justiz ermittelt wegen Steuerbetrugs. Lang hatte sich von Epstein auch Reisen und Fahrdienste zahlen lassen.
Das Außenministerium schaltete zudem die Justiz ein, um gegen einen Diplomaten zu ermitteln, der auf einem Posten bei der UNO enge Kontakte zu Epstein gepflegt hatte. Der Franzose Daniel Siad ist zudem wegen Menschenhandels im Visier der Justiz. Zahlreiche Dokumente in den Epstein-Akten stellen den Mann, der sich als Headhunter für Models beschreibt, als einen bezahlten Mädchenjäger im Auftrag Epsteins dar.
Der bis in höchste Kreise von Politik und Wirtschaft vernetzte US-Investor Epstein soll mehr als tausend Minderjährige und junge Frauen missbraucht und teils an Prominente weitergereicht haben. Er war 2008 wegen Anstiftung einer Minderjährigen zur Prostitution verurteilt worden. 2019 wurde er wegen des Verdachts auf sexuellen Missbrauch von Minderjährigen festgenommen und beging nach offiziellen Angaben in seiner New Yorker Gefängniszelle Suizid.